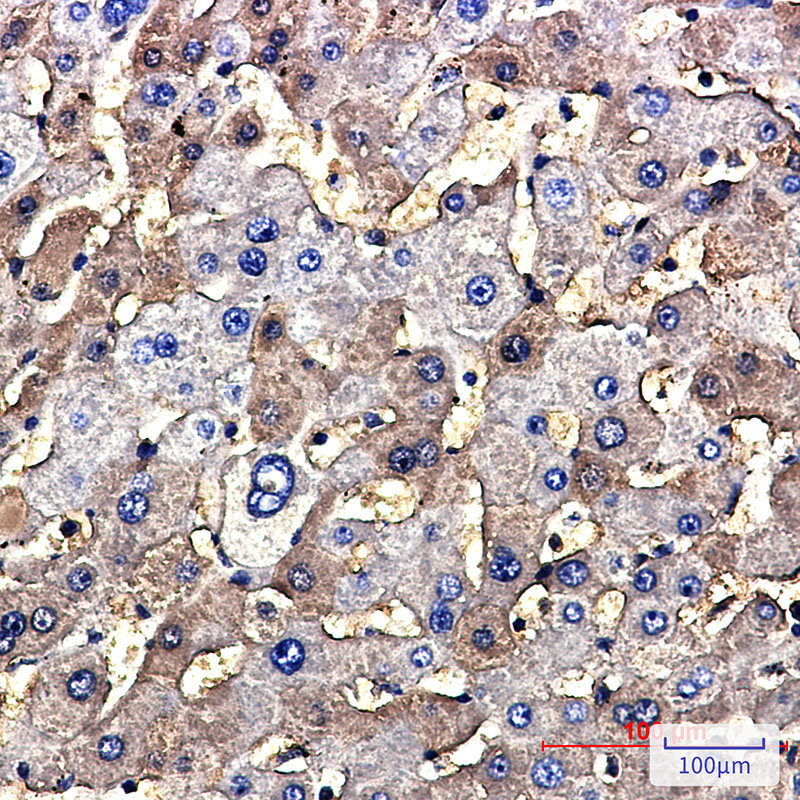

-
分类: 科研抗体货号: P22618别名: NAE2; UBE1C; hUBA3应用: WB反应种属: Human,Mouse
-
分类: 科研抗体货号: P22628别名: Ubiquitin carboxyl terminal hydrolase 22; Usp22; USP3L应用: WB,IP反应种属: Human,Mouse,Rat
-
分类: 科研抗体货号: P22617别名: TSC2; Tuberous sclerosis 2 homolog protein; Tuberous sclerosis 2 protein; Tuberin; TSC4应用: WB,IP,IHC反应种属: Human
-
分类: 科研抗体货号: P22627别名: UEF; FCHL; MLTF; FCHL1; MLTFI; HYPLIP1; bHLHb11应用: WB反应种属: Human,Mouse
-
分类: 科研抗体货号: P22651别名: Protein 61K; hPrp31; U4/U6 snRNP 61 kDa protein应用: WB,IF反应种属: Human,Mouse,Rat
-
分类: 科研抗体货号: P22626别名: FLJ25987; MGC8385; ubiquitin B; Ubiquitin; UBCEP1; UBCEP2; RPS27A应用: WB,IHC,IF反应种属: Human
-
分类: 科研抗体货号: P22649别名: HCAK1; Ig kappa chain C region; IGKC; IMMUNOGLOBULIN InV; Km应用: WB,IHC,IF反应种属: Human
-
分类: 科研抗体货号: P22625别名: E4; UFD2; HDNB1; UBOX3; UFD2A应用: WB,IF反应种属: Human,Rat
-
分类: 科研抗体货号: P22647别名: BAP1; DING; BAP-1; HIPI3; RING2; RING1B应用: WB,IHC反应种属: Human
-
分类: 科研抗体货号: P22624别名: Ubiquitin-protein ligase E3A; UBE3A; E6AP; EPVE6AP; HPVE6A应用: WB,IP,IF反应种属: Human,Mouse,Rat

鄂公网安备42018502007531号
鄂公网安备42018502007531号

